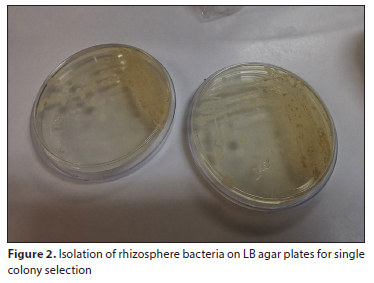

Services on Demand
Journal
Article
Indicators
Related links
-
 Cited by Google
Cited by Google -
 Similars in Google
Similars in Google
Share
Water SA
On-line version ISSN 1816-7950Print version ISSN 0378-4738
Water SA vol.50 n.4 Pretoria Oct. 2024
https://doi.org/10.17159/wsa/2024.v50.i4.4092
TECHNICAL NOTE
Innovative Juncus effusus plant biofilter for enhanced ammonia removal: design, construction, and preliminary testing
Tinashe MunhembaI; Isobel C BrinkI; Thomas E CloeteII; Adele BosmanI
IDepartment of Civil Engineering, Water and Environmental Engineering Group, Stellenbosch University, Private Bag X1, Matieland 7602, South Africa
IISchool for Climate Studies, Stellenbosch University, Private Bag X1, Matieland 7602, South Africa
ABSTRACT
A developing trend in stormwater treatment and management is the use of green technologies. Plant biofilters have been gaining increasing use in support of green technology objectives. This technical note reports on the development and preliminary testing of a laboratory-scale plant biofilter prototype for ammonia removal using a South African native plant species (Juncus effusus). The prototype design was based on a conceptual model for nitrogen fixation, plant uptake, bacterial nitrification and soil sorption. Additionally, a plug compartment was incorporated into the design to simulate plug flow as part of the conceptual model. Biofilter models with and without inoculated bacteria were compared. Ammonia reduction, nitrite and nitrate formation were observed. Results showed that the inoculated plant biofilter performed best, with an average of 61% reduction in ammonia within the filter compared to 15% in the normal plant biofilter. The incorporation of a plug compartment aided in slowing down the ammonia infiltration rate, increasing the retention time, and allowing for nitrification to occur.
Keywords: Juncus effusus, plug compartment, rhizosphere, prototype, ammonia
INTRODUCTION
With increased worldwide urbanisation, stormwater runoff has become an increasing source of pollution. In urban areas, stormwater runoff is often drained to constructed waterways or open water bodies, which can have adverse pollution effects in the receiving waters. Green infrastructure practices such as plant biofilters can provide an inexpensive, affordable, and flexible method of treating stormwater runoff (Patterson and Haught, 2021).
Plant biofiltration systems use vegetation (with concomitant symbiotic microbial groups) in conjunction with granular filtration as an efficient method for removing pollutants from water. However, despite their widespread application, detailed research on the underlying mechanisms and efficiency optimisation of these systems is lacking. Although practical trial-and-error applications of such systems have been incorporated worldwide, detailed research into the functioning and subsequent modelling of such systems is lacking.
The primary research problem addressed in this study is the need for a better understanding of the design parameters and performance factors that enhance ammonia removal in plant biofiltration systems. This technical note aims to provide information on the design, construction, and preliminary results of a laboratory-scale plant biofilter for ammonia removal. The system design was based on the conceptual mathematical model by Jacklin et al. (2022) for testing model validation in future research. A native South African plant species (Juncus effusus), previously found to have been a good addition to an efficient plant biofilter for ammonia removal by Jacklin et al. (2021b), was used in the design.
The prototype design discussed here, therefore, includes additional refinements to the basic plant biofilter design used in Jacklin et al. (2021b), in the form of bacterial inoculation and a plug flow compartment, specifically designed towards improving ammonia removal efficiency as informed by the conceptual mathematical model of Jacklin et al. (2022).
Bacteria, biofilms and their processes
The plant rhizosphere area consists of the rhizosphere (soil surrounding the root), the rhizoplane (the root/soil interface), and the histoplane (the root interior). This serves as a habitat for a diverse range of microorganisms, with the zone closest to the roots typically being the area with a higher density of microorganisms (Mendes et al., 2013; Mukhtar et al., 2019). In plant biofilters, the roots release oxygen and exudates, which promote bacterial growth. The bacteria adhere to the roots and form biofilms (Zhang et al., 2014). The roots and biofilms both perform biogeochemical processes to remove contaminants from polluted water (Li et al., 2018; Shahid et al., 2020; Zhang et al., 2016). It is these processes that are valuable in green infrastructure (GI) applications towards pollutant reduction in stormwater runoff.
Biofilm formation on the substratum is of critical importance and must be aided as far as possible. The prevention of bacterial washout as the stormwater flows through the filter is paramount. Here, with the ability of the biofilms to form in areas of adequate nutrition (Chen et al., 2020), a logical area of focus is to try to ensure that the rate of growth of the bacteria is greater than the washout rate.
Therefore, to try to limit wash-out rates, a plug compartment was envisioned as part of the conceptual design as put forth by Jacklin et al. (2022).
In this plant biofilter laboratory setup, the isolation, cultivation, and subsequent inoculation of rhizosphere bacteria into a suitable soil media in a plant biofilter were included to increase the potential to improve phytoremediation and nutrient breakdown. Even though there is a readily available number of microorganisms within the rhizosphere, adding an additional source of live organisms was presumed to aid the process and was subsequently tested.
Nitrogen fixation by rhizosphere bacteria
In the rhizosphere, nitrate and nitrogen fixation are the main processes that transform nitrogenous compounds via ammonification, nitrification, denitrification, and anaerobic oxidation of ammonia (Bañeras Vives et al., 2012). In plant biofilters, reactive nitrogen is provided by microbes as they perform the nitrogen fixation processes. This is supported by an ample supply of oxygen from roots, which in turn favours the enrichment of nitrogen metabolising bacteria in the rhizosphere (Vitousek et al., 2002). The main use for nitrite and ammonia is for catabolism in microorganisms (Chen et al., 2020). Root systems also play a role in nitrogen fixation by reducing the amount of nitrogen gas as well as adjusting the pH and redox potential within the rhizosphere (Shahid et al., 2020).
In plant biofilters, inorganic forms of nitrogen are mainly present in NH4+ and NO3- ions, with varying data available on its treatment and removal (Barron et al., 2019). The exact removal process for inorganic-N in a biofilter differs based on its design, as some promote nitrification processes that require large amounts of oxygen and other designs promote anaerobic processes (Read et al., 2009). Removal of inorganic-N is primarily done through nitrification and denitrification processes by bacteria and formed biofilms, along with subsequent uptake by plants. In this study, the plant biofilter dosing water was oxygenated to help support nitrification over denitrification. In typical vegetated biofilters, both processes tend to take place at the same time, while unvegetated biofilters, or those with poorly selected plant species, have denitrification as the dominant process (Payne et al., 2014b).
In biofilters there are multiple factors that influence nitrification, not limited to the following (Chen et al., 2020):
• The possibility of several unaerated zones
• The amount of dissolved oxygen available to ensure the maximum growth rate for the microbes can be reached
• The pH in the filter (the growth rate of nitrifying bacteria is reduced by pH that is not in the 7-8 range)
• The hydraulic load conditions - ecause ammonia is dissolved, the retention time affects the concentration of ammonia within the reactor and subsequent effluent
Plant selection
Plant selection is one of the most vital steps in the design of a plant biofilter, as different plants are suited to the removal of different pollutants. Various studies have been conducted that explore the effectiveness of plants in the treatment of wastewater and stormwater in filters as well as in other GI-type treatment systems, such as constructed wetlands. Bratieres et al. (2008) found that the use of plants in biofilters impacts their performance and the efficiency of how the removal processes work. They enhance the physiochemical properties of the soil, adding material for the energy required for microbial activities. The physical and morphological trait differences of plants in a biofilter determine their effectiveness when treating different contaminants (Payne et al., 2014a; Read et al., 2008). For instance, studies have shown that the characteristics of plant ro ots are directly linked to nutrient removal capabilities. This is because plants with deep fibrous roots, and with a great length of roots, offer a greater surface area for microbial action to take place (Read et al., 2009). Plant roots, therefore, act as a substratum for biofilm formation, allowing for the root-bacteria complex to work in tandem, which enhances the removal of nutrients and organic pollutants from stormwater (Tanner and Headley, 2011).
The use of plants in stormwater biofiltration systems has shown improved results in removing N, with different plant species showing varying results in their efficacy. However, growth-stimulating substances that are vital for plant growth can be fatal to microorganisms when in excess; these include ammonia, phosphates, and nitrates. Therefore, in such cases, the choice of plants for remediation of waters polluted with such chemicals is important (Hermawan et al., 2018).
In this study, Juncus effusus, a native hardy South African rush species, was used. Further examples of its use in various applications such as biofilters, constructed wetlands, floating wetlands, and green roof systems can be found in the following texts: Bebba et al. (2019), Garcia Chance et al. (2019), Jacklin et al. (2021a), and White et al. (2011).
MATERIALS AND METHODS
Model background
Jacklin et al. (2022) suggested using the biofilter as a quasi-plug-flow (biofilm) reactor, which is used in wastewater treatment industries. Based on the general principle of a biofilm reactor which utilises microorganism growth on a substratum, adsorption of wastewater particles by microorganisms, and use of degraded particles for microorganism growth, they suggested adopting biofilm modelling equations to subsequently model nutrient removal in biofilters. This approach formed the basis of the current research.
The mathematical model is based on the following principles in the case of N-compounds:
• The ammonia enters the biofilm in the bulk liquid phase
• Development of a biofilm on the provided substratum (soils and roots)
• Removal of ammonia via diffusion into the biofilm
• Plant and soil media aid in the removal processes via plant uptake and encapsulation by media
• Accounting for water uptake by plants and water loss due to evaporation and transpiration
The biofilm diffusion processes, plant uptake, soil sorption, and water loss mechanisms were considered for the development of the model. Morgenroth (2008) provided the following equation to account for the diffusion mechanics occurring in the biofilm.

where: JLF = flux at the biofilm surface from the bulk liquid layer into the biofilm, AF = surface area of the biofilm within a plug compartment, VB = bulk liquid phase volume of a plug compartment.
This then represents a setting in which the immobile biofilm has one side in contact with the particles and the other with the substratum; the particles then move into the biofilm until equilibrium has been reached. As this is a complex process, the addition of a plug compartment is implemented. This mimics plug-flow reactor design, which is described in the experimental section. This configuration allows for previously studied biofilm constants and assumptions to be applied in the case of a biofilter, with the main areas of study being the biofilm parameters such as density and thickness (further discussion in the experimental section). Because density and thickness are parameters that can be measured, according to Jacklin et al. (2022) the flux in a given plug of a bio filter will then occur over the bio film according to the following reaction:

where: rFi. = rate of substrate conversation for state parameter i, = stoichiometric coefficient of state parameter i for process rate j, Pj = rate of process j. Here, the various constants and equations for modelling rFi can be found in Ekama and Wentzel (2020), based on the autotrophic or heterotrophic type of study. Due to the scope of this study, only autotrophic organisms were considered, as these are the main organisms considered for ammonia removal.
Due to the addition of plants to the biofilter, a more complex equation is introduced (Jacklin et al., 2022):

where: fcp = pollutant to plant biomass relationship, Fc = nutrient preference factor, Δz = thickness of a plug compartment, Lgm= entire length of the growth media, kgp (C, T, I) = plant growth rate as a function of the pollutant concentration, temperature, and sunlight, krp (T) = plant dark respiration rate as a function of temperature, kep (T, I) = plant photorespiration rate as a function of temperature and sunlight, kmp (T) = plant mortality rate as a function of temperature.
This equation considers nutrient uptake and biofilm parameters. However, it includes a temperature-dependent differential section and requires research to inform the initial assumptions, as described in the experimental work section. Following the work presented here, an alternative experimental and stoichiometric method to account for plant uptake was subsequently explored and developed.
Design background
The N-removal conceptual mathematical model used in this design, which will be tested in future research with the laboratory plant biofilter for validation, was based on the work by Jacklin et al. (2022). Salient items pertaining to the laboratory setup design, as well as additions to or deviations from this conceptual model, are included here.
The main parameters focused on during the experimental design, setup, and testing were ammonia, nitrates, and nitrites, along with biofilm length, thickness, density, and bacterial growth rates. To aid the nitrification process in becoming the dominant process in the plant biofilter plug compartment, the dosing water was highly oxygenated. Further to this, a bacteria-enhanced rhizosphere was created to allow the use of the soil cover around the plant roots as a substratum for biofilm formation.
The conceptual mathematical N-removal model in Jacklin et al. (2022) was based on the mass balance approach below:
{Change of mass in a plug} = {mass increase via flow into the plug} - {mass decrease via flow out of the plug} ± {mass change via adsorption and desorption} ± {mass change via diffusion to or from the biofilm} - {mass change due to plant uptake or release}
Inflow concentrations of ammonia were calculated and dosed into a known inflow rate to calculate the masses into the plug. It must be noted that inflow ammonia concentrations in plant biofilters must inform the choice of plant and substratum to be used, as high doses of ammonia will cause the soil pH to rise and create ammonium toxicity. This is not only detrimental to plant growth but also to biofilm formation (Rogato et al., 2010).
The setup was designed to capture and test the concentrations of ammonia, nitrates, and nitrites out of the plug. From Jacklin et al. (2022), flow is calculated as:

where: Qinf = influent flow into the plug compartment, Qeff = effluent flow out of the plug compartment, Qet = evapotranspiration rate. This holds true for a completely saturated plug compartment. In some cases, where evapotranspiration is not negligible and when the plug is not fully saturated, the loss of water due to drying during the drying phase will not directly result in a change of pollutant mass in a plug compartment; however, the concentration of the dissolved pollutants will increase as the volume of water decreases.
It is possible that adsorption and desorption for nitrates may be found to be negligible since they are a mobile compound in water and easily leach (Pandiyan et al., 2021). In the case of ammonia and ammonium in soil, ammonia may undergo volatilisation, adsorption, or transformation via microbial nitrification. Volatilisation is unlikely to occur as it is a process that mainly occurs on the soil surface at high pH values (Chen, 1997). In this experimental design, lime was added as a stabiliser to maintain a pH of around 7. This then allows the further assumption that ammonia will adsorb to the soil, allowing the biofilm colonies to make use of the adsorbed ammonia and convert it via nitrification. It must be noted that this assumption will be tested in future research and, at this stage, only forms part of the design approach.
Mass change due to diffusion into/from the biofilm is a biological process that is mainly determined by how the biofilm interacts with the nutrients and its ability to complete the nitrification process. A minimum retention time for the nutrients within the system was calculated through the use of the equations provided by Ekama and Wentzel (2020). Although this model was based on sludge retention time (SRT), it was used as a basis to calculate the minimum amount of time required for nitrification to take place in the presence of nitrifying organisms, as was the focus of the equation. In addition, because nitrifiers at different locations within the biofilm have different metabolisms and rates at which they metabolise nutrients (Williamson Kerry et al., 2012), making use of the minimum SRT found from the equations it was expected that even the slow metabolising cells within the rhizosphere have time to metabolise.

where: μAmT = maximum specific growth rate at a specific temperature, Na = the ammonia concentration in the reactor, Nae = effluent ammonia concentration, KnT = half saturation constant at a specific temperature, bAT = specific endogenous mass loss rate for nitrifiers at a specific temperature, SRT = sludge retention time (Ekama and Wentzel, 2020).
Common literature values for μAm are available. In a laboratory investigation such as this it is also possible to sample near the roots to determine the growth rate of the nitrifiers in the particular plant biofilter. In addition, to support the value obtained for SRT, biofilm density and thickness tests can be performed to support the notion that biofilms had enough time to develop and proliferate to perform the nitrification in the allotted amount of time.
Mass change due to plant uptake was simplified in this experimental design by including a control composed of a biofilter without vegetation for determining plant uptake. To create a more complete and detailed determination of the nutrient uptake within the plant, the reader is referred to this subject in Jacklin et al. (2022).
Biofilter design
Four biofilters were constructed from PVC piping of diameter 110 mm and length 600 mm, following the work in Jacklin et al. (2022). Each column had growth media consisting of a loamy soil and compost mixture for plant acclimatation and growth, a transition layer of sand, and a drainage layer of gravel (Fig. 1). A stainless-steel sieve with a perforated plastic covering was added as a plug compartment separator to create a compartment that reduces flow velocity and allows for the calculated retention time. This was added at the average root depth for J. effusus. A separate plastic catchment tube was added at the root depth to collect samples directly from the plug compartment, while a separate drainage tap was added at the sealed bottom to collect an end sample for comparison.
Experimental design
Out of the 4 columns, 2 were planted and 2 controls were not planted. A planted and unplanted column was enriched with a prepared culture of isolated rhizosphere bacteria. One planted column was not enriched, to act as a standard control for the enriched column and one unplanted column was not enriched, to act as the control for the experiment. Juncus effusus plants sourced from a local nursery were transplanted into the columns and watered with municipal tap water for a period of 5 weeks to allow for plant establishment. Fertiliser was added during the transplantation process to aid in the establishment of the plants. A relatively high ammonia compound dosage of 10 mg/L was selected, with a calculated required retention time in the plug compartment of 4 days, using diammonium phosphate as the dosing chemical. The dosage selection was aimed at aiding analytical results analysis (consistent effluent values of 0 would not provide much insight; variability was required) and to enable investigation into performance under high concentration conditions, identify potential limitations, and develop strategies to improve efficiency and reliability. The retention time was calculated using the SRT equation provided by Ekama and Wentzel. (2020) above, with 20°C as the standard temperature of the experiment, which was conducted in a climate-controlled room. Dosing water was oxygenated prior to plant biofilter dosing with an air bubbler, in an attempt to ensure aerobic conditions towards enabling nitrification as the dominant process. Additionally, 550-900 nm wavelength plant grow lights were used in the plant biofilter setups.
Rhizosphere isolation and culture
The method used for the isolation, culturing, and inoculation of rhizosphere bacteria was a combination of existing methods. The process can be separated into 3 parts:
• Harvesting of plant roots and rhizosphere sample
• Isolation and culture of rhizosphere bacteria
• Inoculation of bacteria into designated biofilters
Although isolation and identification of a single strain of rhizosphere bacteria is possible, it did not fall within the scope of this research. Hence, the isolation and cultivation of all bacterial strains present in the soil sample was conducted.
The isolation and cultivation of the rhizosphere bacteria were performed under sterile conditions at the University of Stellenbosch Microbiology Department under BioSafety Level 1 protocols following the methods outlined in Harrigan (1966) and Yarrow (1998). A root sample of Juncus effusus was taken. Making use of a sterile scalpel, the roots and stems were divided, and a subsample of the root was placed into (PSS) physiological saline solution (containing 0.89% NaCl) for 30 mins at 23°C, allowing the microorganisms on the root surface to be removed and enter the solution for the isolation stage.
After the required timespan had elapsed, the root samples were removed, and the remaining PSS solution was serially diluted by adding 1 mL of root sample solution to a test tube containing 9 mL PSS solution. From this solution, 100 μL were transferred to a second test tube containing 9.9 mL PSS solution, and the same step was repeated for a third test tube. The samples were all vortexed to ensure adequate mixing; 1 mL and 100 μL of each sample were spread plated onto LB agar plates that were supplemented with 0.02% (w/v) chloramphenicol, an anti-fungal, to allow for only bacterial microorganisms to grow on the plates. Multiple plates were spread to allow for easy selection of bacterial colonies for streaking. The plates were incubated at 26°C for 48 h.
After incubation, single colonies from the best plates were selected and streak-plated onto LB agar plates (Fig. 2). These streak plates ensured easy selection for cultivation (Fig. 3). The isolation was done under sterile conditions and, therefore, it was assumed that the single colonies were a type of rhizosphere bacteria.
Single colonies were selected from the streaked plates and inoculated into a flask containing 100 mL of LB broth. The flasks were placed onto shakers and incubated for 24 h to allow for bacterial growth, after which serial dilutions of the inoculum were performed as above and the optical density measured to determine colony cell count. An optical density of 0.526 and a final cell concentration of 2.63 x 108 cells/mL was achieved and selected to be inoculated into the biofilters; this cell density was selected as an initial standard after dilution, after the methods suggested by Harrigan (1966).
A 100 mL suspension of the cell concentration was added to one planted biofilter and one control unplanted biofilter. The suspension was mixed into the soil before dosing began. 1.5 L of the thoroughly mixed diammonium phosphate dosing liquid was used in each of the biofilters, and samples were collected on the 2nd, 3rd, and 4th day from the effluent and compartments before a new dosing run was implemented. Before a new dosing run, the biofilters were drained of the previous liquid before a new 1.5 L dose was introduced.
During the dosing phase, soil pH and temperature measurements were undertaken. The soil pH increased to pH > 8 due to the dosing with 10 mg/L ammonia with a high DO content. Therefore, 5mL of 35% sulphuric acid mixed with 100 mL deionised water was added to the soil, which decreased the soil pH to an acceptable 7.03. The internal temperature of the biofilters was also measured and was found to be cooler (18°C) than the set room temperature (20°C). Therefore, any future modelling investigations should consider that the plant biofilter temperature should be measured as input to the model parameters.
For testing and analysis, samples were collected from the biofilter effluents as well as from the plug compartments. Before testing, samples were passed through 0.45 μm nylon syringe filters to focus only on dissolved nutrients. The samples were tested for ammonia, nitrites, and nitrates at the BIOGRIP Node for Water and Soil Biogeochemistry at Stellenbosch University. The total oxidisable nitrogen (TON), nitrite, and ammonia levels were quantified using the Skalar BluVision Discrete Analyser. For the biofilm analysis, biofilm samples were collected from the plug compartment separator and analysed at the CAF Microscopy Unit, at Stellenbosch University, using a confocal fluorescence microscope. Samples were dyed using a fluorescent dye to visualise the microorganisms, with the live microorganisms showing a green fluorescence and the dead microorganisms showing a red fluorescence (Fig. 4).
RESULTS AND DISCUSSION
Effluent analysis
Table 1 indicates that in the normal plant biofilter (not inoculated), the ammonia concentration decreased by 15% between the first and last sampling days, as measured in the effluent, with evidence of nitrite and nitrate in the effluent of the same filter. The nitrite concentration was reduced (65%) from the first day to the last day of testing, and the nitrate concentration increased from <MDL (method detection limit) to 1.11 mg/L. This indicates that ammonia was nitrified in this time with a decrease in concentration from 10 mg/L (initial dose) to 3.3 mg/L. Within the compartment, the ammonia levels increased (582%) as sampling days passed. This indicates that ammonia was contained within the plug compartment as designed, with nitrite levels also increasing (+32%) over the same period. The increase in ammonia in the compartment may have been partly due to fertiliser residue. However, increases also occurred during dosing days, indicating that the plug compartment worked as designed to slow ammonia movement and increase retention time. Nitrate levels in this filter were below the detectable limits. Further investigation into this occurrence is warranted and may have been due to the inhibition of nitrite-oxidising bacteria due to pH or temperature (Jiménez et al., 2011).
The results for the plant biofilter that was inoculated with bacteria showed a decrease in ammonia levels, similar to, but larger than, the normal vegetated biofilter (64% vs 15%), indicating that bacterial inoculation improved performance. Nitrite levels showed an increase in concentration (70%) with nitrate levels again being undetectable. This further indicates that nitrification was occurring within the biofilter, keeping in mind that the original ammonia dose was 10mg/L. The ammonia levels within the compartment increased (1 067%) over the first and last day of the testing period, possibly due to the plug compartment design, as explained above.
The control effluent ammonia concentrations increased, indicating that there was some ammonia residue from the fertiliser in the system. The compartment also showed an increase in ammonia (1.5 mg/L to 2.1 mg/L), probably for the same reason.
The control inoculated with bacteria showed similar results in terms of an increase in nutrient concentrations in its effluent, when compared to the vegetated inoculated biofilter (Table 1). Nitrates were recorded within the compartment as well.
These results indicate that the plant biofilter performed as designed based on comparing the inoculated filters to those without, with the plug compartment increasing retention time of ammonia and the inoculum improving nitrification. Future research and modelling can therefore be used to optimise the design.
Biofilm analysis
Samples were collected from each of the four plant biofilters to assess bacterial growth and biofilm formation. Two different sections of the substratum (A and B) in a filter were viewed to ascertain whether there was consistency in growth occurring over the used substratum.
In the inoculated control, results showed bacterial growth (Fig. 5). However, biofilm formation and adhesion was minimal, with a greater number of live cells (green) over dead cells (red) (Fig. 5). This indicated that the bacteria were growing at a rate faster than the death rate to maintain their population, but without a suitable substratum to form intact biofilms. Maintaining a live bacterial population within the filter led to assuming that the washout rate was minimal.
The un-inoculated plant biofilter showed biofilm formation, with an abundance of live cells compared to dead cells and good interaction and adherence (Fig. 4). The biofilm clusters were more pronounced but had separations between them. This may have been due to root growth separating or disturbing the biofilm surroundings. Compared to the inoculated control biofilter, it can be inferred that plant exudates supported bacterial growth and health.
The un-inoculated control filter showed an obvious lack of bacterial growth and almost no biofilm growth (Fig. 6). This is in clear contrast to the inoculated control (Fig. 5), which indicated that the inoculated bacteria can survive within the loamy soil (at least for a short period of time), but to form a niche microbial community, there must be an external source of bacteria. This can be done either by pre-inoculation with bacteria or by gaining the microbial community from plants.
The inoculated plant biofilter showed a greater density of biofilm formation when compared to all other filters, with interaction between the biofilms (Fig. 7). A formation of live cells encapsulating the dead cells as the biofilm forms was shown. This, when compared to the un-inoculated (normal) plant biofilter and the inoculated control filter, suggests that plant root systems, as well as bacterial inoculation, are vital to optimal plant biofilter functioning. A 3D view of the interactions can be seen in Fig. 8.
CONCLUSIONS
This technical note reported on the development of a plant biofilter using the native South African plant Juncus effusus for enhanced ammonia removal in stormwater treatment. The study aimed to optimise the biofilter's design, focusing on improving retention times and fostering effective microbial and plant interaction. A key innovation in the design was the incorporation of a plug compartment, which played a significant role in controlling retention times, thereby facilitating proper functioning of the symbiotic rhizosphere bacterial-plant system. The system demonstrated effective ammonia reduction, and the presence of nitrites and nitrates indicated successful nitrification. In addition, rhizosphere bacteria inoculation of the rhizosphere showed improved bacterial biofilm formation as well as improved ammonia removal by the system. Overall, the results indicate that the plant biofilter design was successful. Further experimentation toward design optimisation and design modelling is warranted.
AUTHOR CONTRIBUTIONS
Tinashe Munhemba: conceptualization, methodology, investigation, set up of experimental design, data collection and analysis, visualization, writing of original draft. Isobel C Brink: experimental design supervision, data analysis, interpretation of results and review draft. Thomas E Cloete: data analysis, interpretation of results and review draft (microbial section). Adele Bosman: data analysis, interpretation of results and revision after review.
ORCID
Adele Bosman: https://orcid.org/0000-0001-7375-6130
REFERENCES
BAÑERAS VIVES L, RUIZ RUEDA O, LÓPEZ I FLORES R, QUINTANA POU X and HALLIN S (2012) The role of plant type and salinity in the selection for the denitrifying community structure in the rhizosphere of wetland vegetation. Int. Microbiol. 15 89-99. https://doi.org/10.2436/20.1501.01.162 [ Links ]
BARRON NJ, DELETIC A, JUNG J, FOWDAR H, CHEN Y and HATT BE (2019) Dual-mode stormwater-greywater biofilters: The impact of alternating water sources on treatment performance. Water Res. 159 521-537. https://doi.org/10.1016/j.watres.2019.04.020 [ Links ]
BASHIR K, TODAKA D, RASHEED S, MATSUI A, AHMAD Z, SAKO K, UTSUMI Y, VU AT, TANAKA M, TAKAHASHI S and co-authors (2022) Ethanol-mediated novel survival strategy against drought stress in plants. Plant Cell Physiol. 63 1181-1192. https://doi.org/10.1093/pcp/pcac114 [ Links ]
BEBBA AA, LABED I, ZEGHDI S and MESSAITFA A (2019) Purification performance of Typha latifolia, Juncus effusus and Papyrus cyperus in arid climate: influence of seasonal variation. J. Water Chem. Technol. 41 396-401. https://doi.org/10.1007/978-3-031-07559-9 [ Links ]
BRATIERES K, FLETCHER TD, DELETIC A and ZINGER Y (2008) Nutrient and sediment removal by stormwater biofilters: a large-scale design optimisation study. Water Res. 42 (14) 3930-3940. https://doi.org/10.1016/j.watres.2008.06.009 [ Links ]
CHAMPANERIA A and RAJKUMAR S (2022) Selection of carbon sources by rhizobacteria - a muster of signalling factors governing carbon catabolite repression. In: Sayyed RZ and Uarrota VG (eds) Secondary Metabolites and Volatiles of PGPR in Plant-Growth Promotion. Springer International Publishing, Cham. [ Links ]
CHEN G, LOOSDRECHT MCM, EKAMA GA and BRDJANOVIC D (2020) Biological Wastewater Treatment. IWA Publishing, London. [ Links ]
DONLAN RM (2002) Biofilms: microbial life on surfaces. Emerg. Infect. Dis. 8 881-890. https://doi.org/10.3201/eid0809.020063 [ Links ]
EKAMA GA and WENTZEL MC (2020) Nitrogen removal. In: Ekama GA, Wentzel MC, Van Loosdrecht MCM and Chen G (eds.) Biological Wastewater Treatment: Principles, Modeling and Design. IWA Publishing, London. https://doi.org/10.2166/9781789060362_0161 [ Links ]
GARCIA CHANCE LM, VAN BRUNT SC, MAJSZTRIK JC and WHITE SA (2019) Short and long-term dynamics of nutrient removal in floating treatment wetlands. Water Res. 159 153-163. https://doi.org/10.1016/j.watres.2019.05.012 [ Links ]
HARRIGAN WF and McCANCE ME (1966) Statistical methods for the selection and examination of microbial colonies. In: Laboratory Methods in Microbiology. Academic Press, London. 34-35. https://doi.org/10.1016/B978-1-4832-3205-8.50014-3 [ Links ]
HERMAWAN AA, JUNG D and TALEI A (2018) Removal process of nutrients and heavy metals in tropical biofilters. E3S Web of Conferences. https://doi.org/10.1051/e3sconf/20186505026 [ Links ]
JACKLIN D, VAN DER MERWE I and BRINK I (2022) A suitible deterministic modeling approach of urban stormwater nutrient, metal and organic pollutant removal in plant biofiltration. Urb. Water J. 19 975-991. https://doi.org/10.1080/1573062X.2022.2105240 [ Links ]
JACKLIN D, BRINK IC and JACOBS SM (2021a) Exploring the use of indigenous Western Cape plants as potential water and soil pollutant phytoremediators with a focus on green infrastructure. Water SA 47(3 July). https://doi.org/10.17159/wsa/2021.v47.i3.11860 [ Links ]
JACKLIN D, BRINK IC and JACOBS SM (2021b) A phyto-guide to species selection for optimized South African green infrastructure. Water SA 47 (4) 515-522. https://doi.org/10.17159/wsa/2021.v47.i4.3875 [ Links ]
JIMÉNEZ E, GIMÉNEZ JB, RUANO MV, FERRER J and SERRALTA J (2011) Effect of pH and nitrite concentration on nitrite oxidation rate. Bioresour. Technol. 102 8741-8747. https://doi.org/10.1016/j.biortech.2011.07.092 [ Links ]
LI C, LIU M, HU Y, SHI T, ZONG M and WALTER MT (2018) Assessing the Impact of urbanization on direct runoff using improved composite CN method in a large urban area. Int. J. Environ. Res. Publ. Health 15 775. https://doi.org/10.3390/ijerph15040775 [ Links ]
MENDES R, GARBEVA P and RAAIJMAKERS JM (2013) The rhizosphere microbiome: significance of plant beneficial, plant pathogenic, and human pathogenic microorganisms. FEMS Microbiol. Rev. 37 634-663. https://doi.org/10.1111/1574-6976.12028 [ Links ]
MUKHTAR S, MEHNAZ S, MIRZA MS and MALIK KA (2019) Isolation and characterization of bacteria associated with the rhizosphere of halophytes (Salsola stocksii and Atriplex amnicola) for production of hydrolytic enzymes. Braz. J. Microbiol. 50 85-97. https://doi.org/10.1007/s42770-019-00044-y [ Links ]
PANDIYAN B, ANNAPOORANI E, SRIDEVI S, MANGOTTIRI V, SARAGUR S and NARAYANAN N (2021) Nitrate sequestration and sorption capacity in soil under varying organic loading conditions. Sust. Pract. Innov. Civ. Eng. 14. https://doi.org/10.1007/978-981-15-5101-7_14 [ Links ]
PATTERSON CL and HAUGHT RC (2021) Chapter 6 - Regulatory considerations to ensure clean and safe drinking water. In: Ahuja S (ed.) Handbook of Water Purity and Quality (2nd edn). Academic Press, Amsterdam. 200 pp. https://doi.org/10.1016/B978-0-12-821057-4.00012-4 [ Links ]
PAYNE E, PHAM T, COOK PLM, FLETCHER TD, HATT BE and DELETIC A (2014a) Biofilter design for effective nitrogen removal from stormwater - influence of plant species, inflow hydrology and use of a saturated zone. Water Sci. Technol. 69 1312-1319. https://doi.org/10.2166/wst.2014.013 [ Links ]
PAYNE EGI, FLETCHER TD, COOK PLM, DELETIC A and HATT BE (2014b). Processes and drivers of nitrogen removal in stormwater biofiltration. Crit. Rev. Environ. Sci. Technol. 44 796-846. https://doi.org/10.1080/10643389.2012.741310 [ Links ]
READ J, FLETCHER TD, WEVILL T and DELETIC A (2009) Plant traits that enhance pollutant removal from stormwater in biofiltration systems. Int. J. Phytoremed. 12 34-53. https://doi.org/10.1080/15226510902767114 [ Links ]
READ J, WEVILL T, FLETCHER TD and DELETIC A (2008) Variation among plant species in pollutant removal from stormwater in biofiltration systems. Water Res. 42 893-902. https://doi.org/10.1016/j.watres.2007.08.036 [ Links ]
SHAHID MJ, AL-SURHANEE AA, KOUADRI F, ALI S, NAWAZ N, AFZAL M, RIZWAN M, ALI B and SOLIMAN MH (2020) Role of microorganisms in the remediation of wastewater in floating treatment wetlands: a review. Sustainability 12 https://doi.org/10.3390/su12145559 [ Links ]
SOBIESZUK P and SZEWCZYK K (2006) Estimation of (C/N) ratio for microbial denitrification. Environ. Technol. 27 103-108. https://doi.org/10.1080/09593332708618624 [ Links ]
TANNER CC and HEADLEY TR (2011) Components of floating emergent macrophyte treatment wetlands influencing removal of stormwater pollutants. Ecol. Eng. 37 474-486. https://doi.org/10.1016/j.ecoleng.2010.12.012 [ Links ]
VITOUSEK PM, CASSMAN K, CLEVELAND C, CREWS T, FIELD CB, GRIMM NB, HOWARTH RW, MARINO R, MARTINELLI L and RASTETTER EB (2002) Towards an ecological understanding of biological nitrogen fixation. Biogeochemistry 57 1-45. https://doi.org/10.1007/978-94-017-3405-9_1 [ Links ]
WHITE LJ, BRÖZEL VS and SUBRAMANIAN S (2015) Isolation of rhizosphere bacterial communities from soil. Bio-protocol 5 1569. https://doi.org/10.21769/BioProtoc.1569 [ Links ]
WHITE S, NYBERG E, SEDA B and GLENN J (2011) Nutrient remediation by Canna flaccida and Juncus effusus in floating treatment wetlands. Poster Board #291. In: ASHS Annual Conference, 23-30 September 2011, Waikoloa. [ Links ]
WILLIAMSON KS, RICHARDS A, PEREZ-OSORIO C, PITTS B, MCINNERNEY K, STEWART S and FRANKLIN MJ (2012) Heterogeneity in Pseudomonas aeruginosa biofilms includes expression of ribosome hibernation factors in the antibiotic-tolerant subpopulation and hypoxia-induced stress response in the metabolically active population. J. Bacteriol. 194 2062-2073. https://doi.org/10.1128/jb.00022-12 [ Links ]
YARROW D (1998) Methods for the isolation, maintenance and identification of yeasts. The Yeasts 4 77-100. https://doi.org/10.1016/B978-044481312-1/50014-9 [ Links ]
ZHANG CB, LIU WL, PAN XC, GUAN M, LIU SY, GE Y and CHANG J 2014. Comparison of effects of plant and biofilm bacterial community parameters on removal performances of pollutants in floating island systems. Ecol. Eng. 73 58-63. https://doi.org/10.1016/j.ecoleng.2014.09.023 [ Links ]
ZHANG L, ZHAO J, CUI N, DAI Y, KONG L, WU J and CHENG S (2016) Enhancing the water purification efficiency of a floating treatment wetland using a biofilm carrier. Environ. Sci. Pollut. Res. 23 7437-7443. https://doi.org/10.1007/s11356-015-5873-9 [ Links ]
 Correspondence:
Correspondence:
Adele Bosman
Email:abosman2@sun.ac.za
Received: 14 July 2023
Accepted: 14 October 2024













